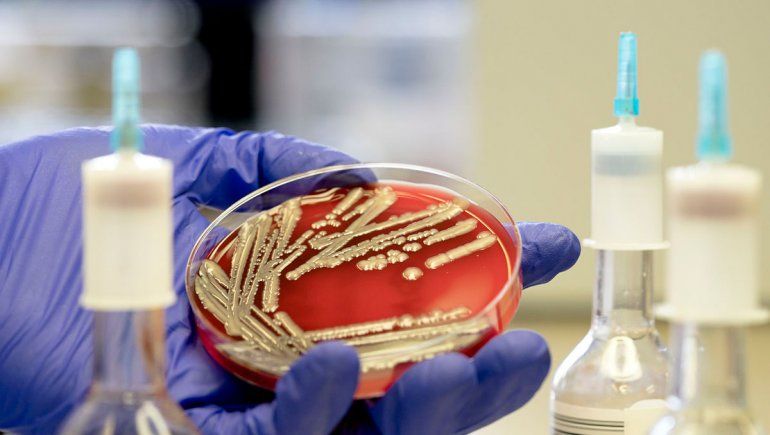

Por Ana Laura Calducci - [email protected]
El verano apenas empezó y Neuquén ya está entre las provincias del país con mayor tasa de incidencia del síndrome urémico hemolítico. La enfermedad afecta a bebés y niños pequeños y puede producir insuficiencia renal de por vida. En lo que va de 2019, se registraron 15 casos, nueve autóctonos y otros seis de pacientes provenientes de localidades cercanas de Río Negro y La Pampa.
Como la enfermedad se incrementa con el calor, en esta época del año hay que estar más atentos que nunca a los primeros síntomas. Es que durante la última década, la mitad de los casos se produjeron entre diciembre y enero.
Para prevenir el síndrome, desde el Ministerio de Salud neuquino aconsejan llevar a los chiquitos de inmediato al médico ante cualquier tipo de diarrea y extremar los cuidados con los alimentos, la higiene doméstica y el agua de ríos y piletas durante la época de calor.
En nuestra provincia, la propagación de la enfermedad se mantiene alta desde 2013, con alrededor de ocho casos confirmados por año. La excepción fue 2015, cuando se llegó al récord de 16 pacientes con el síndrome. Casi la mitad de los pequeños tratados tenía entre 2 y 4 años, en coincidencia con el grupo etario de mayor riesgo.
En 2018, Neuquén y Chubut compartieron el primer lugar a nivel nacional en incidencia del síndrome urémico hemolítico. Ambas provincias tuvieron una tasa de 11 casos cada 100 mil menores de 5 años. A nivel nacional, el promedio fue de siete.
Este año, el Ministerio de Salud ya registró 15 casos del síndrome en nuestra provincia. De esos pacientes, nueve eran neuquinos y se incluyen en la estadística sanitaria, en tanto que otros seis se atendieron en hospitales o clínicas locales pero eran turistas o familias que estaban de paso, oriundas de Río Negro y La Pampa.
Con esos nueve casos autóctonos registrados, Neuquén se mantiene entre las cinco provincias con mayor incidencia del síndrome en lo que va de este 2019, junto con Tierra del Fuego, Chubut, Santa Cruz y Río Negro.
Al igual que Neuquén, la Patagonia es la región del país con la mayor tasa de incidencia de la enfermedad. Para colmo, a su vez, Argentina está ente las naciones del mundo con más casos de síndrome urémico hemolítico en chiquitos de edad preescolar.
En los últimos años, la enfermedad se convirtió en la principal causa pediátrica de insuficiencia renal aguda y la segunda de insuficiencia renal crónica a nivel nacional. Uno de cada cinco trasplantes de riñón en niños y adolescentes argentinos son consecuencia de este síndrome.
Cómo prevenir la enfermedad
El síndrome urémico hemolítico se contrae a través del contacto con alimentos en mal estado o agua contaminada y falta de higiene. Hasta el 90 por ciento de los casos se producen como un trastorno secundario tras una infección gastrointestinal con un subtipo de la bacteria fecal Escherichia coli.
Tanto las personas adultas como la mayoría de los animales domésticos (incluidos perros y gatos) pueden ser portadores de la enfermedad sin síntomas evidentes e igual contagiar a los niños pequeños, el grupo de mayor riesgo.
Para prevenir el síndrome hay que controlar el buen estado de carnes, lácteos y jugos. También verificar la fecha de vencimiento y la cadena de frío.
Otra medida es lavar frutas, verduras y envases de bebidas antes de guardarlos en la heladera y evitar la contaminación cruzada al manipular alimentos crudos y cocidos.
Además, hay que lavarse las manos antes de comer y después de ir al baño o cambiar pañales y estar atento a la contaminación del agua en ríos, lagos y piletas.
La enfermedad tarda de dos a diez días en incubarse. Después del comienzo de la diarrea, que es el primer síntoma evidente, el paciente puede contagiar a otros. Otras señales de alarma son la piel pálida, vómitos, convulsiones y dolor de estómago.
LEÉ MÁS
Te puede interesar...